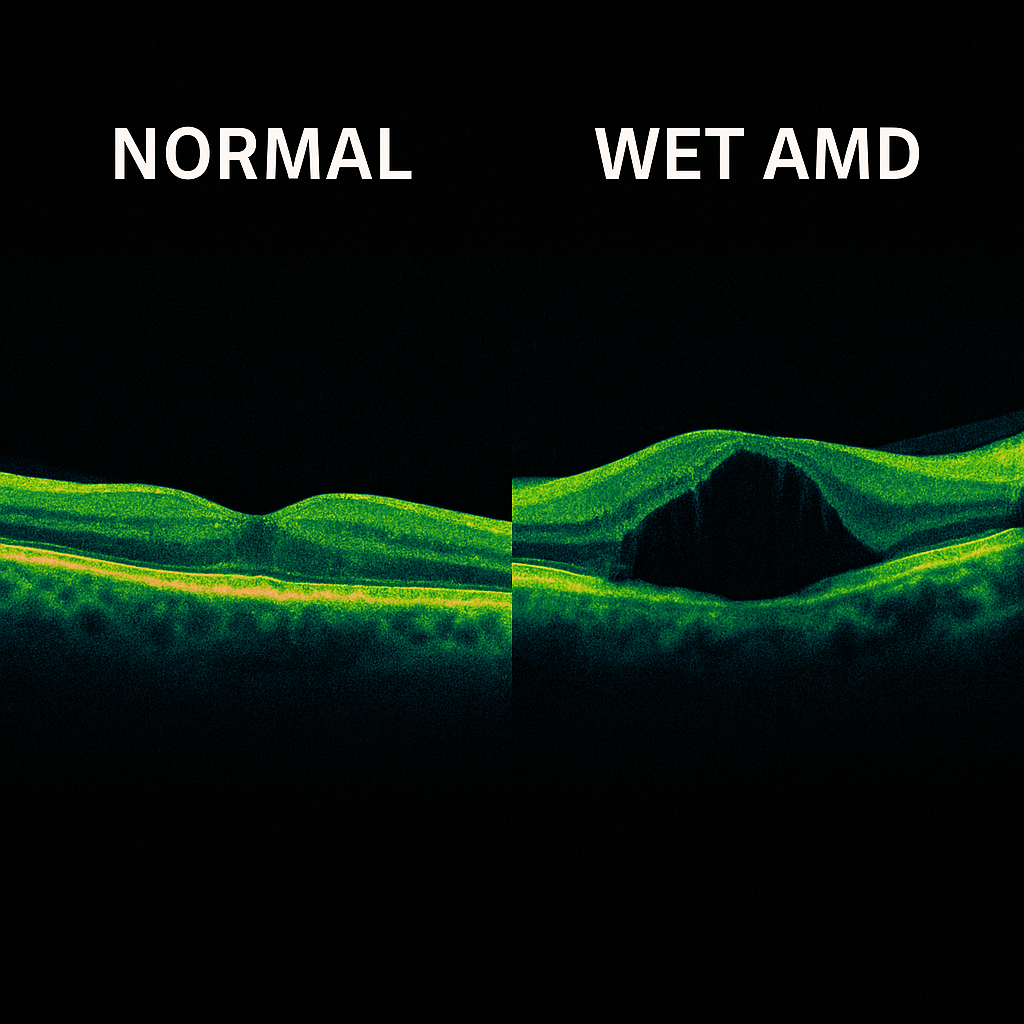

Macular Degeneration
Macular degeneration—often called age-related macular degeneration (AMD)—is a chronic eye condition that affects the macula, the central part of the retina responsible for sharp, detailed vision. The macula allows us to read, drive, recognize faces, and see fine detail. When it begins to deteriorate, the center of your vision can become blurred or distorted, while the peripheral (side) vision usually remains intact.
AMD is one of the leading causes of vision loss in adults over 50, affecting millions worldwide. There are two main types:
Dry (non-neovascular) AMD — the more common form, caused by gradual thinning of the macula and the accumulation of tiny deposits called drusen.
Wet (neovascular) AMD — the more advanced form, where abnormal blood vessels grow under the retina, leaking fluid or blood and causing rapid vision loss if untreated.

Symptoms
Macular degeneration typically develops slowly and painlessly. In early stages, you might not notice any change in vision. As it progresses, symptoms can include:
Blurred or fuzzy central vision
Difficulty reading or recognizing faces
Straight lines appearing wavy or distorted (known as metamorphopsia)
A dark or empty spot in the center of vision
Reduced brightness or intensity of colors
Regular comprehensive eye exams are essential—especially if you are over 50 or have a family history of AMD—since early detection can significantly improve outcomes.
Treatment
While there is currently no complete cure for AMD, effective treatments can slow progression and preserve vision. For dry AMD, lifestyle changes and nutritional support can make a difference:
Vitamins with specific formulation of antioxidants and minerals
Healthy diet rich in leafy greens, omega-3 fatty acids, and colorful fruits
Avoiding smoking, which is a major risk factor
UV protection and regular monitoring with Amsler grid testing
When AMD advances to the wet form, treatment focuses on stopping the abnormal blood vessels that leak under the retina. The mainstay of therapy involves intravitreal injections—tiny, in-office injections of medication that reduce swelling and block new vessel growth.
This page is for informational purposes only and does not provide medical advice.
Contact us!
At Nile Eye Care & Surgery, Dr. Tadrosse brings advanced expertise in the diagnosis and management of dry and wet macular degeneration—combining modern imaging technology with individualized treatment plans tailored to each patient’s condition and lifestyle.
Whether you are newly diagnosed, noticing visual changes, or seeking expert management for ongoing treatment, we invite you to schedule an evaluation today.
